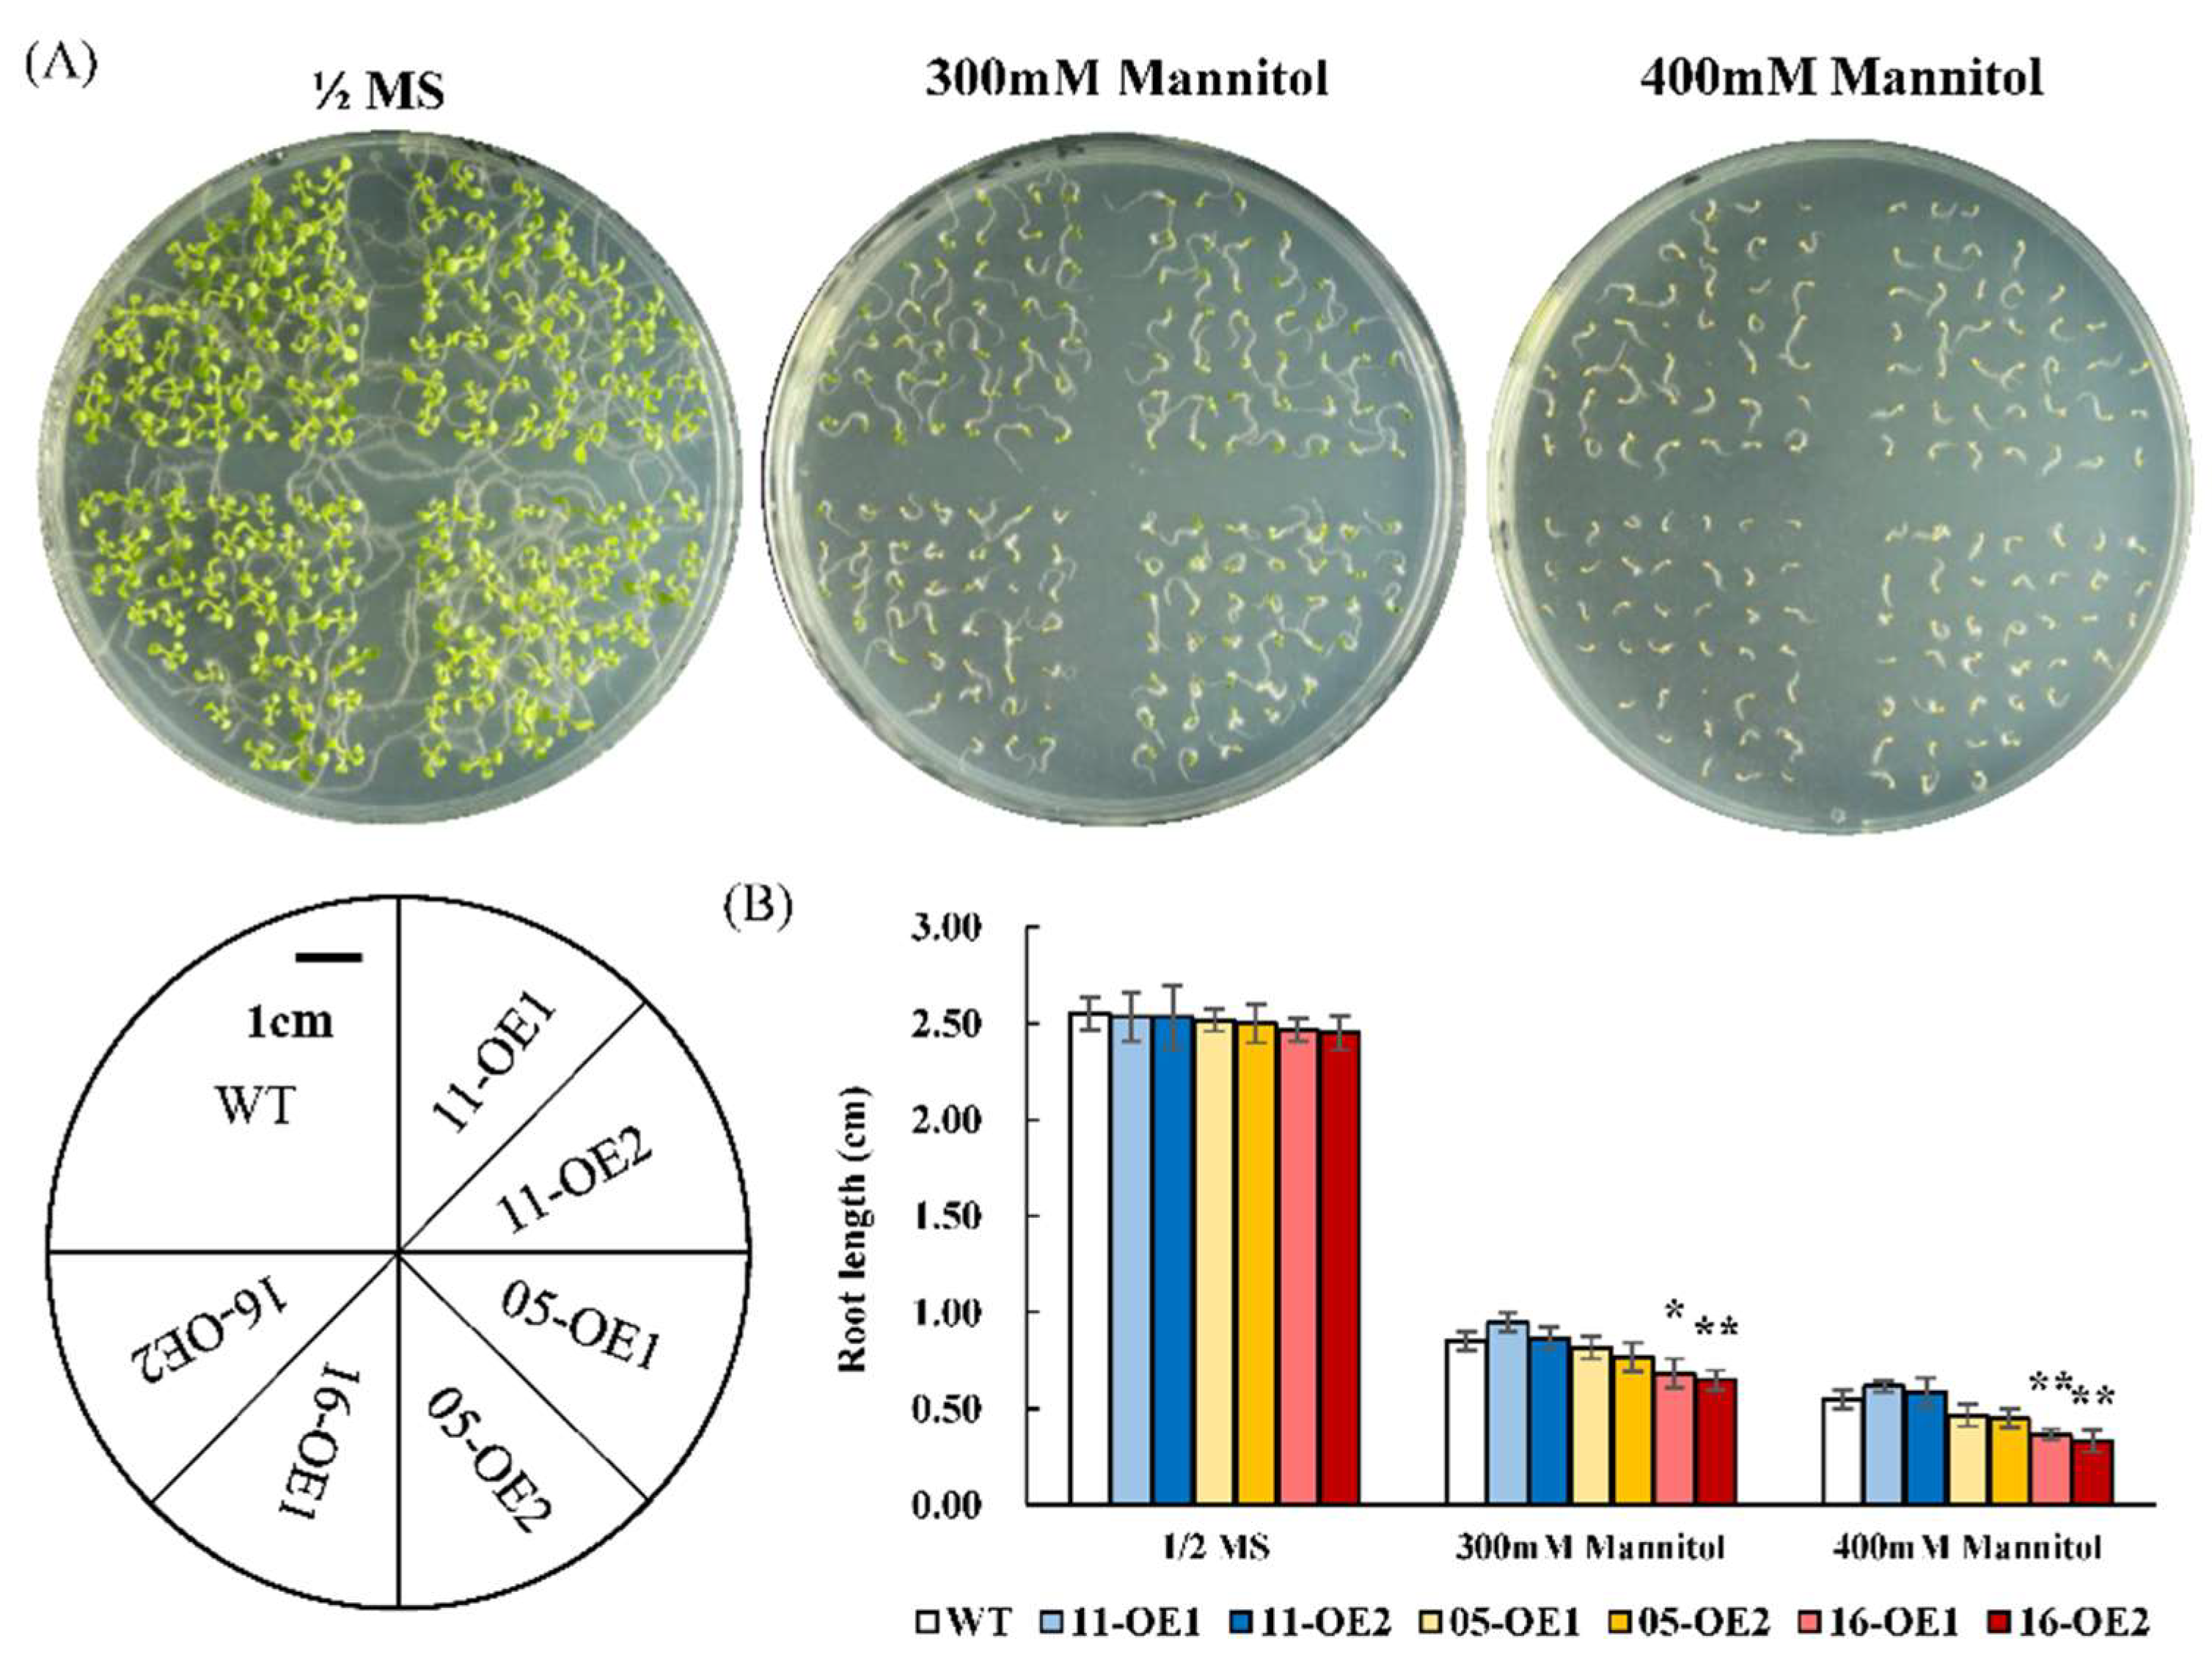
Plants 11 03522 g005 Plants 11 03522 g005

Identification of Peanut AhMYB44 Transcription Factors and Their Multiple Roles in Drought Stress Responses
Abstract
1. Introduction
2. Results
2.1. Six AhMYB44 Genes were Identified in Cultivated Peanut
2.2. Expression Profiles of AhMYB44s
2.3. Subcellular Localization and Transcriptional Activity Analyses of Three AhMYB44 Genes
2.4. Different Tolerances to Drought Stress of AhMYB44s in Arabidopsis
2.5. Expression Pattern Analysis of Stress-Related Genes in Transgenic Arabidopsis Plants
3. Discussion
4. Materials and Methods
4.1. Experimental Materials
4.2. Sequence and Phylogenetic Analysis of AhMYB44s
4.3. Expression Analysis of AhMYB44s
4.4. Subcellular Localization and Transcriptional Activation
4.5. Transformation and Characterization of Transgenic Plants
5. Conclusions
Supplementary Materials
Author Contributions
Funding
Data Availability Statement
Acknowledgments
Conflicts of Interest
References
- Katam, R.; Sakata, K.; Suravajhala, P.; Pechan, T.; Kambiranda, D.M.; Naik, K.S.; Guo, B.; Basha, S.M. Comparative leaf proteomics of drought-tolerant and-susceptible peanut in response to water stress. J. Proteom. 2016, 143, 209–226. [Google Scholar] [CrossRef] [PubMed]
- Zeng, R.; Chen, T.; Wang, X.; Cao, J.; Li, X.; Xu, X.; Chen, L.; Xia, Q.; Dong, Y.; Huang, L.; et al. Physiological and Expressional Regulation on Photosynthesis, Starch and Sucrose Metabolism Response to Waterlogging Stress in Peanut. Front. Plant Sci. 2021, 12, 601771. [Google Scholar] [CrossRef] [PubMed]
- Krishna, G.; Singh, B.K.; Kim, E.-K.; Morya, V.K.; Ramteke, P.W. Progress in genetic engineering of peanut (Arachis hypogaea L.)—A review. Plant Biotechnol. J. 2015, 13, 147–162. [Google Scholar] [CrossRef]
- Bertioli, D.J.; Jenkins, J.; Clevenger, J.; Dudchenko, O.; Gao, D.; Seijo, G.; Leal-Bertioli, S.C.M.; Ren, L.; Farmer, A.D.; Pandey, M.K.; et al. The genome sequence of segmental allotetraploid peanut Arachis hypogaea. Nat. Genet. 2019, 51, 877–884. [Google Scholar] [CrossRef] [PubMed]
- Zhuang, W.; Chen, H.; Yang, M.; Wang, J.; Pandey, M.K.; Zhang, C.; Chang, W.C.; Zhang, L.; Zhang, X.; Tang, R.; et al. The genome of cultivated peanut provides insight into legume karyotypes; polyploid evolution and crop domestication. Nat. Genet. 2019, 51, 865–876. [Google Scholar] [CrossRef] [PubMed]
- Zhu, H.; Jiang, Y.; Guo, Y.; Huang, J.; Zhou, M.; Tang, Y.; Sui, J.; Wang, J.; Qiao, L. A novel salt inducible WRKY transcription factor gene, AhWRKY75, confers salt tolerance in transgenic peanut. Plant Physiol. Biochem. 2021, 160, 175–183. [Google Scholar] [CrossRef]
- Li, C.; Yan, C.; Sun, Q.; Wang, J.; Yuan, C.; Mou, Y.; Shan, S.; Zhao, X. The bHLH transcription factor AhbHLH112 improves the drought tolerance of peanut. BMC Plant Biol. 2021, 21, 540. [Google Scholar]
- Wang, Z.; Yan, L.; Wan, L.; Huai, D.; Kang, Y.; Shi, L.; Jiang, H.; Lei, Y.; Liao, B. Genome-wide systematic characterization of bZIP transcription factors and their expression profiles during seed development and in response to salt stress in peanut. BMC Genom. 2019, 20, 51. [Google Scholar] [CrossRef]
- Yuan, C.; Li, C.; Lu, X.; Zhao, X.; Yan, C.X.; Wang, J.; Sun, Q.; Shan, S. Comprehensive genomic characterization of NAC transcription factor family and their response to salt and drought stress in peanut. BMC Plant Biol. 2020, 20, 454. [Google Scholar] [CrossRef]
- Chen, N.; Yang, Q.; Pan, L.; Chi, X.; Chen, M.; Hu, D.; Yang, Z.; Wang, T.; Wang, M.; Yu, S. Identification of 30 MYB transcription factor genes and analysis of their expression during abiotic stress in peanut (Arachis hypogaea L.). Gene 2014, 533, 332–345. [Google Scholar] [CrossRef]
- Fang, Y.; Yan, W.; Wu, J.; Yin, D.; Tang, X. Genome-wide identification and bioinformatics analysis of MYB transcription factor family in peanut (Arachis hypogaea). Chin. J. Bioinform. 2021, 19, 116–127. [Google Scholar]
- Rosinski, J.A.; Atchley, W.R. Molecular evolution of the Myb family of transcription factors: Evidence for polyphyletic origin. J. Mol. Evol. 1998, 46, 74–83. [Google Scholar] [CrossRef] [PubMed]
- Dubos, C.; Stracke, R.; Grotewold, E.; Weisshaar, B.; Martin, C.; Lepiniec, L. MYB transcription factors in Arabidopsis. Trends. Plant Sci. 2010, 15, 573–581. [Google Scholar] [CrossRef] [PubMed]
- Butt, H.I.; Yang, Z.; Gong, Q.; Chen, E.; Wang, X.; Zhao, G.; Ge, X.; Zhang, X.; Li, F. GaMYB85, an R2R3 MYB gene, in transgenic Arabidopsis plays an important role in drought tolerance. BMC Plant Biol. 2017, 17, 142. [Google Scholar] [CrossRef]
- Prouse, M.B.; Campbell, M.M. The interaction between MYB proteins and their target DNA binding sites. Biochim. Biophys. Acta. 2012, 1819, 67–77. [Google Scholar] [CrossRef]
- Wang, X.; Niu, Y.; Zheng, Y. Multiple Functions of MYB Transcription Factors in Abiotic Stress Responses. Int. J. Mol. Sci. 2021, 22, 6125. [Google Scholar] [CrossRef]
- Xiao, R.; Zhang, C.; Guo, X.; Li, H.; Lu, H. MYB Transcription Factors and Its Regulation in Secondary Cell Wall Formation and Lignin Biosynthesis during Xylem Development. Int. J. Mol. Sci. 2021, 22, 3560. [Google Scholar] [CrossRef]
- Shin, R.; Burch, A.Y.; Huppert, K.A.; Tiwari, S.B.; Murphy, A.S.; Guilfoyle, T.J.; Schachtman, D.P. The Arabidopsis transcription factor MYB77 modulates auxin signal transduction. Plant Cell 2007, 19, 2440–2453. [Google Scholar] [CrossRef]
- Lü, B.B.; Li, X.J.; Sun, W.W.; Li, L.; Gao, R.; Zhu, Q.; Tian, S.M.; Fu, M.Q.; Yu, H.L.; Tang, X.M.; et al. AtMYB44 regulates resistance to the green peach aphid and diamondback moth by activating EIN2-affected defences in Arabidopsis. Plant Biol. 2013, 15, 841–850. [Google Scholar] [CrossRef]
- Zou, B.; Jia, Z.; Tian, S.; Wang, X.; Gou, Z.; Lü, B.; Dong, H. AtMYB44 positively modulates disease resistance to Pseudomonas syringae through the salicylic acid signalling pathway in Arabidopsis. Funct. Plant Biol. 2013, 40, 304–313. [Google Scholar] [CrossRef]
- Qiu, Z.; Yan, S.; Xia, B.; Jiang, J.; Yu, B.; Lei, J.; Chen, C.; Chen, L.; Yang, Y.; Wang, Y.; et al. The eggplant transcription factor MYB44 enhances resistance to bacterial wilt by activating the expression of spermidine synthase. J. Exp. Bot. 2019, 70, 5343–5354. [Google Scholar] [CrossRef] [PubMed]
- Zhou, X.; Zha, M.; Huang, J.; Li, L.; Imran, M.; Zhang, C. StMYB44 negatively regulates phosphate transport by suppressing expression of PHOSPHATE1 in potato. J. Exp. Bot. 2017, 68, 1265–1281. [Google Scholar] [CrossRef] [PubMed]
- Wei, Z.Z.; Hu, K.D.; Zhao, D.L.; Tang, J.; Huang, Z.Q.; Jin, P.; Li, Y.H.; Han, Z.; Hu, L.Y.; Yao, G.F.; et al. MYB44 competitively inhibits the formation of the MYB340-bHLH2-NAC56 complex to regulate anthocyanin biosynthesis in purple-fleshed sweet potato. BMC Plant Biol. 2020, 20, 258. [Google Scholar] [CrossRef] [PubMed]
- Li, L.X.; Wei, Z.Z.; Zhou, Z.L.; Zhao, D.L.; Tang, J.; Yang, F.; Li, Y.H.; Chen, X.Y.; Han, Z.; Yao, G.F.; et al. A single amino acid mutant in the EAR motif of IbMYB44.2 reduced the inhibition of anthocyanin accumulation in the purple-fleshed sweetpotato. Plant Physiol. Biochem. 2021, 167, 410–419. [Google Scholar] [CrossRef] [PubMed]
- Wei, L.; Mao, W.; Jia, M.; Xing, S.; Ali, U.; Zhao, Y.; Chen, Y.; Cao, M.; Dai, Z.; Zhang, K.; et al. FaMYB44.2, a transcriptional repressor, negatively regulates sucrose accumulation in strawberry receptacles through interplay with FaMYB10. J. Exp. Bot. 2018, 69, 4805–4820. [Google Scholar] [CrossRef]
- Nakabayashi, R.; Yonekura-Sakakibara, K.; Urano, K.; Suzuki, M.; Yamada, Y.; Nishizawa, T.; Matsuda, F.; Kojima, M.; Sakakibara, H.; Shinozaki, K.; et al. Enhancement of oxidative and drought tolerance in Arabidopsis by overaccumulation of antioxidant flavonoids. Plant J. 2014, 77, 367–379. [Google Scholar] [CrossRef]
- Wang, F.; Kong, W.; Wong, G.; Fu, L.; Peng, R.; Li, Z.; Yao, Q. AtMYB12 regulates flavonoids accumulation and abiotic stress tolerance in transgenic Arabidopsis thaliana. Mol. Genet. Genom. 2016, 291, 1545–1559. [Google Scholar] [CrossRef]
- Seo, P.J.; Lee, S.B.; Suh, M.C.; Park, M.J.; Go, Y.S.; Park, C.M. The MYB96 transcription factor regulates cuticular wax biosynthesis under drought conditions in Arabidopsis. Plant Cell. 2011, 23, 1138–1152. [Google Scholar] [CrossRef]
- Lee, S.B.; Kim, H.U.; Suh, M.C. MYB94 and MYB96 Additively Activate Cuticular Wax Biosynthesis in Arabidopsis. Plant Cell Physiol. 2016, 57, 2300–2311. [Google Scholar] [CrossRef]
- Cominelli, E.; Galbiati, M.; Vavasseur, A.; Conti, L.; Sala, T.; Vuylsteke, M.; Leonhardt, N.; Dellaporta, S.L.; Tonelli, C. A guard-cell-specific MYB transcription factor regulates stomatal movements and plant drought tolerance. Curr. Biol. 2005, 15, 1196–1200. [Google Scholar] [CrossRef]
- Oh, J.E.; Kwon, Y.; Kim, J.H.; Noh, H.; Hong, S.W.; Lee, H. A dual role for MYB60 in stomatal regulation and root growth of Arabidopsis thaliana under drought stress. Plant Mol. Biol. 2011, 77, 91–103. [Google Scholar] [CrossRef] [PubMed]
- Jung, C.; Seo, J.S.; Han, S.W.; Koo, Y.J.; Kim, C.H.; Song, S.I.; Nahm, B.H.; Choi, Y.D.; Cheong, J.J. Overexpression of AtMYB44 enhances stomatal closure to confer abiotic stress tolerance in transgenic Arabidopsis. Plant Physiol. 2008, 146, 623–635. [Google Scholar] [CrossRef] [PubMed]
- Jaradat, M.R.; Feurtado, J.A.; Huang, D.; Lu, Y.; Cutler, A.J. Multiple roles of the transcription factor AtMYBR1/AtMYB44 in ABA signaling, stress responses, and leaf senescence. BMC Plant Biol. 2013, 13, 192. [Google Scholar] [CrossRef] [PubMed]
- Li, D.; Li, Y.; Zhang, L.; Wang, X.; Zhao, Z.; Tao, Z.; Wang, J.; Wang, J.; Lin, M.; Li, X.; et al. Arabidopsis ABA receptor RCAR1/PYL9 interacts with an R2R3-type MYB transcription factor, AtMYB44. Int. J. Mol. Sci. 2014, 15, 8473–8490. [Google Scholar] [CrossRef]
- Huang, Y.; Zhao, H.; Gao, F.; Yao, P.; Deng, R.; Li, C.; Chen, H.; Wu, Q. A R2R3-MYB transcription factor gene, FtMYB13, from Tartary buckwheat improves salt/drought tolerance in Arabidopsis. Plant Physiol. Biochem. 2018, 132, 238–248. [Google Scholar] [CrossRef] [PubMed]
- Upadhyay, R.K.; Gupta, A.; Ranjan, S.; Singh, R.; Pathre, U.V.; Nath, P.; Sane, A.P. The EAR motif controls the early flowering and senescence phenotype mediated by over-expression of SlERF36 and is partly responsible for changes in stomatal density and photosynthesis. PLoS ONE 2014, 9, e101995. [Google Scholar] [CrossRef] [PubMed]
- Nguyen, N.H.; Cheong, J.J. AtMYB44 interacts with TOPLESS-RELATED corepressors to suppress protein phosphatase 2C gene transcription. Biochem. Biophys. Res. Commun. 2018, 507, 437–442. [Google Scholar] [CrossRef]
- Xiong, H.; Li, J.; Liu, P.; Duan, J.; Zhao, Y.; Guo, X.; Li, Y.; Zhang, H.; Ali, J.; Li, Z. Overexpression of OsMYB48-1, a Novel MYB-Related Transcription Factor, Enhances Drought and Salinity Tolerance in Rice. PLoS ONE 2014, 9, e92913. [Google Scholar] [CrossRef]
- Yin, X.; Cui, Y.; Wang, M.; Xia, X. Overexpression of a novel MYB-related transcription factor, OsMYBR1, confers improved drought tolerance and decreased ABA sensitivity in rice. Biochem. Biophys. Res. Commun. 2017, 490, 1355–1361. [Google Scholar] [CrossRef]
- Chen, Z.; Hong, X.; Zhang, H.; Wang, Y.; Li, X.; Zhu, J.K.; Gong, Z. Disruption of the cellulose synthase gene, AtCesA8/IRX1, enhances drought and osmotic stress tolerance in Arabidopsis. Plant J. 2005, 43, 273–283. [Google Scholar] [CrossRef]
- Kishor, P.; Hong, Z.; Miao, G.H.; Hu, C.; Verma, D. Overexpression of [delta]- Pyrroline-5-Carboxylate Synthetase increases proline production and confers osmotolerance in transgenic plants. Plant Physiol. 1995, 108, 1387–1394. [Google Scholar] [CrossRef] [PubMed]
- Funck, D.; Baumgarten, L.; Stift, M.; von Wirén, N.; Schönemann, L. Differential contribution of P5CS isoforms to stress tolerance in Arabidopsis. Front. Plant Sci. 2020, 11, 565134. [Google Scholar] [CrossRef] [PubMed]
- Yang, D.; Ni, R.; Yang, S.; Pu, Y.; Qian, M.; Yang, Y.; Yang, Y. Functional characterization of the Stipa purpurea P5CS gene under drought stress conditions. Int. J. Mol. Sci. 2021, 22, 9599. [Google Scholar] [CrossRef] [PubMed]
- Xu, Z.; Wang, M.; Guo, Z.; Zhu, X.; Xia, Z. Identification of a 119-bp promoter of the Maize Sulfite Oxidase gene (ZmSO) that confers high-level gene expression and ABA or drought inducibility in transgenic plants. Int. J. Mol. Sci. 2019, 20, 3326. [Google Scholar] [CrossRef]
- Abe, H.; Urao, T.; Ito, T.; Seki, M.; Shinozaki, K.; Yamaguchi-Shinozaki, K. Arabidopsis AtMYC2 (bHLH) and AtMYB2 (MYB) function as transcriptional activators in abscisic acid signaling. Plant Cell 2003, 15, 63–78. [Google Scholar] [CrossRef]
- Chen, H.; Lai, L.; Li, L.; Liu, L.; Jakada, B.H.; Huang, Y.; He, Q.; Chai, M.; Niu, X.; Qin, Y. AcoMYB4; an Ananas comosus L. MYB transcription factor, functions in osmotic stress through negative regulation of ABA signaling. Int. J. Mol. Sci. 2020, 21, 5727. [Google Scholar] [CrossRef]
- Lavenus, J.; Goh, T.; Roberts, I.; Guyomarc’h, S.; Lucas, M.; De, S.I.; Fukaki, H.; Beeckman, T.; Bennett, M.; Laplaze, L. Lateral root development in Arabidopsis: Fifty shades of auxin. Trends Plant Sci. 2013, 18, 450–458. [Google Scholar] [CrossRef]
- Zhao, Y.; Xing, L.; Wang, X.; Hou, Y.J.; Gao, J.; Wang, P.; Duan, C.G.; Zhu, X.; Zhu, J.K. The ABA receptor PYL8 promotes lateral root growth by enhancing MYB77-dependent transcription of auxin-responsive genes. Sci. Signal 2014, 7, ra53. [Google Scholar] [CrossRef]
- Weber, H.; Borisjuk, L.; Wobus, U. Molecular physiology of legume seed development. Annu. Rev. Plant Biol. 2005, 56, 253–279. [Google Scholar] [CrossRef]
- Kumar, R.; Pandey, M.K.; Roychoudhry, S.; Nayyar, H.; Kepinski, S.; Varshney, R.K. Peg Biology: Deciphering the Molecular Regulations Involved During Peanut Peg Development. Front. Plant Sci. 2019, 10, 1289. [Google Scholar] [CrossRef]
- Liu, H.; Liang, X.; Lu, Q.; Li, H.; Liu, H.; Li, S.; Varshney, R.; Hong, Y.; Chen, X. Global transcriptome analysis of subterranean pod and seed in peanut (Arachis hypogaea L.) unravels the complexity of fruit development under dark condition. Sci. Rep. 2020, 10, 13050. [Google Scholar] [CrossRef] [PubMed]
- Li, W.; Huang, L.; Liu, N.; Pandey, M.K.; Chen, Y.; Cheng, L.; Guo, J.; Yu, B.; Luo, H.; Zhou, X.; et al. Key Regulators of Sucrose Metabolism Identified through Comprehensive Comparative Transcriptome Analysis in Peanuts. Int. J. Mol. Sci. 2021, 22, 7266. [Google Scholar] [CrossRef] [PubMed]
- Lescot, M.; Déhais, P.; Thijs, G.; Marchal, K.; Moreau, Y.; Van de Peer, Y.; Rouzé, P.; Rombauts, S. PlantCARE, a database of plant cis-acting regulatory elements and a portal to tools for in silico analysis of promoter sequences. Nucleic Acids Res. 2002, 30, 325–327. [Google Scholar] [CrossRef] [PubMed]
- Thompson, J.D.; Gibson, T.J.; Plewniak, F.; Jeanmougin, F.; Higgins, D.G. The CLUSTAL_X windows interface: Flexible strategies for multiple sequence alignment aided by quality analysis tools. Nucleic Acids Res. 1997, 25, 4876–4882. [Google Scholar] [CrossRef] [PubMed]
- Piast, M.; Kustrzeba-Wójcicka, I.; Matusiewicz, M.; Banaś, T. Molecular evolution of enolase. Acta. Biochim. Pol. 2005, 52, 507–513. [Google Scholar] [CrossRef] [PubMed]
- Tamura, K.; Peterson, D.; Peterson, N.; Stecher, G.; Nei, M.; Kumar, S. MEGA5: Molecular evolutionary genetics analysis using maximum likelihood, evolutionary distance; and maximum parsimony methods. Mol. Biol. Evol. 2011, 28, 2731–2739. [Google Scholar] [CrossRef]
- Chen, C.; Chen, H.; Zhang, Y.; Thomas, H.R.; Frank, M.H.; He, Y.; Xia, R. TBtools: An integrative toolkit developed for interactive analyses of big biological data. Mol. Plant. 2020, 13, 1194–1202. [Google Scholar] [CrossRef]
- Su, L.C.; Deng, B.; Liu, S.; Li, L.M.; Hu, B.; Zhong, Y.T.; Li, L. Isolation and characterization of an osmotic stress and ABA induced histone deacetylase in Arachis hygogaea. Front. Plant Sci. 2015, 6, 512. [Google Scholar] [CrossRef]
- Li, X.Y.; Liu, X.; Yao, Y.; Li, Y.H.; Liu, S.; He, C.Y.; Li, J.M.; Lin, Y.Y.; Li, L. Overexpression of Arachis hypogaea AREB1 gene enhances drought tolerance by modulating ROS scavenging and maintaining endogenous ABA content. Int. J. Mol. Sci. 2013, 14, 12827–12842. [Google Scholar] [CrossRef]
- Kim, J.M.; To, T.K.; Matsui, A.; Tanoi, K.; Kobayashi, N.I.; Matsuda, F.; Habu, Y.; Ogawa, D.; Sakamoto, T.; Matsunaga, S.; et al. Acetate-mediated novel survival strategy against drought in plants. Nat. Plants. 2017, 3, 17097. [Google Scholar] [CrossRef]
- Bai, S.; Tao, R.; Tang, Y.; Yin, L.; Ma, Y.; Ni, J.; Yan, X.; Yang, Q.; Wu, Z.; Zeng, Y.; et al. BBX16, a B-box protein, positively regulates light-induced anthocyanin accumulation by activating MYB10 in red pear. Plant Biotechnol. J. 2019, 17, 1985–1997. [Google Scholar] [CrossRef] [PubMed]
- Hartmann, M.; Gas-Pascual, E.; Hemmerlin, A.; Rohmer, M.; Bach, T.J. Development of an image-based screening system for inhibitors of the plastidial MEP pathway and of protein geranylgeranylation. F1000Reseach 2015, 4, 14. [Google Scholar] [CrossRef]
- Kumar, K.R.; Kirti, P.B. Differential gene expression in Arachis diogoi upon interaction with peanut late leaf spot pathogen; Phaeoisariopsis personata and characterization of a pathogen induced cyclophilin. Plant Mol. Biol. 2011, 75, 497–513. [Google Scholar] [CrossRef] [PubMed]
- Chinnusamy, V.; Ohta, M.; Kanrar, S.; Lee, B.H.; Hong, X.; Agarwal, M.; Zhu, J.K. ICE1: A regulator of cold-induced transcriptome and freezing tolerance in Arabidopsis. Genes Dev. 2003, 17, 1043–1054. [Google Scholar] [CrossRef]
- Clough, S.J.; Bent, A.F. Floral dip: A simplified method for Agrobacterium-mediated transformation of Arabidopsis thaliana. Plant J. 1998, 16, 735–743. [Google Scholar] [CrossRef]
- Perin, E.C.; Crizel, R.L.; Galli, V.; Messias, R.D.; Rombaldi, C.V.; Chaves, F.C. Extraction and quantification of abscisic acid and derivatives in strawberry by LC-MS. Food Anal. Method. 2018, 11, 2547–2552. [Google Scholar] [CrossRef]

| Name | mRNA ID in NCBI | Corresponding Sequence in PeanutBase | Chromosome No. | ORF | Amino Acids | MW (KDa) | PI | ||
|---|---|---|---|---|---|---|---|---|---|
| bp | Homology (%) | aa | Homology (%) | ||||||
| AhMYB44-01 | XM_025841764 | - | Arahy.01 (A1) | 948 | 98.3 | 316 | 99.1 | 34.46 | 9.57 |
| AhMYB44-11 | XM_025771501 | - | Arahy.11 (B1) | 948 | 316 | 34.37 | 9.57 | ||
| AhMYB44-05 | XM_025842871 | Arahy.HL1WF3 | Arahy.05 (A5) | 1056 | 98.8 | 352 | 99.7 | 37.29 | 9.79 |
| AhMYB44-15 | XM_025796710 | Arahy.CPTS0I | Arahy.15 (B5) | 1056 | 352 | 37.32 | 9.79 | ||
| AhMYB44-06 | XM_025751114 | - | Arahy.06 (A6) | 759 | 98.9 | 253 | 98.4 | 27.64 | 8.77 |
| AhMYB44-16 | XM_025804513 | - | Arahy.16 (B6) | 759 | 253 | 27.58 | 8.98 | ||
| Motif | (+: Forward Sequence, −: Reverse Sequence) Distance from ATG | Function | |||||
|---|---|---|---|---|---|---|---|
| AhMYB44-01 | AhMYB44-11 | AhMYB44-05 | AhMYB44-15 | AhMYB44-06 | AhMYB44-16 | ||
| ARE (AAACCA) | (−) 173 | (−) 174, (+) 975 | (−) 144, (−) 919 | (−) 144, (−) 920 | (−) 135, (−) 974 | (+) 573, (−) 995 | Cis-acting regulatory element essential for anaerobic induction |
| CGTCA | (+) 325, (+) 735 | (+) 326 | (+) 312, (−) 719 | (+) 312, (−) 720 | (−) 924 | (−) 945 | Cis-acting regulatory element involved in MeJA responsiveness |
| MBS (CAACTG) | (+) 421 | (+) 422, (+) 806 | - | - | - | - | MYB binding site involved in drought inducibility |
| TATC-box (TATCCCA) | (−) 300 | (−) 301 | (−) 287 | - | - | - | Cis-acting element involved in gibberellin responsiveness |
| GARE (TCTGTTG) | - | (+) 620 | - | - | - | - | Gibberellin-responsive element |
| GC motif (CCCCCG) | - | (+) 717 | (+) 1247 | (+) 1248 | - | - | Enhancer-like element involved in anoxic-specific inducibility |
| O2 site (GATGATGTGG/ GATGACATGG) | - | (−) 1130 | (−) 1132 | (−) 1133 | - | - | Cis-acting regulatory element involved in zein metabolism regulation |
| ABRE (ACGTG/ CACGTA) | - | - | (−) 588, (−) 811, (−) 1182, (+) 1183, (−) 1346 | (−) 592, (−) 812, (−) 1183, (+) 1184, (−) 1347 | (−) 266 | (−) 278 | Cis-acting element involved in abscisic acid responsiveness |
| LTR (CCGAAA) | - | - | (−) 1292 | (−) 1293 | - | (−) 1265 | Cis-acting element involved in low-temperature responsiveness |
| TC-rich repeats (GTTTTCTTAC) | - | - | (−) 840 | (−) 841 | - | - | Cis-acting element involved in defense and stress responsiveness |
Publisher’s Note: MDPI stays neutral with regard to jurisdictional claims in published maps and institutional affiliations. |
© 2022 by the authors. Licensee MDPI, Basel, Switzerland. This article is an open access article distributed under the terms and conditions of the Creative Commons Attribution (CC BY) license (https://creativecommons.org/licenses/by/4.0/).
Share and Cite
Liu, Y.; Shen, Y.; Liang, M.; Zhang, X.; Xu, J.; Shen, Y.; Chen, Z. Identification of Peanut AhMYB44 Transcription Factors and Their Multiple Roles in Drought Stress Responses. Plants 2022, 11, 3522. https://doi.org/10.3390/plants11243522
Liu Y, Shen Y, Liang M, Zhang X, Xu J, Shen Y, Chen Z. Identification of Peanut AhMYB44 Transcription Factors and Their Multiple Roles in Drought Stress Responses. Plants. 2022; 11(24):3522. https://doi.org/10.3390/plants11243522
Chicago/Turabian StyleLiu, Yonghui, Yue Shen, Man Liang, Xuyao Zhang, Jianwen Xu, Yi Shen, and Zhide Chen. 2022. "Identification of Peanut AhMYB44 Transcription Factors and Their Multiple Roles in Drought Stress Responses" Plants 11, no. 24: 3522. https://doi.org/10.3390/plants11243522
APA StyleLiu, Y., Shen, Y., Liang, M., Zhang, X., Xu, J., Shen, Y., & Chen, Z. (2022). Identification of Peanut AhMYB44 Transcription Factors and Their Multiple Roles in Drought Stress Responses. Plants, 11(24), 3522. https://doi.org/10.3390/plants11243522

